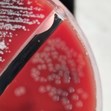
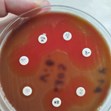

Спасиха жена от "бактерия човекоядец"
- Редактор: Диляна Маринова
- Коментари: 1
Този случай е първият документиран в България, при който пациент оцелява
В Университетската многопрофилна болница за активно лечение (УМБАЛ) Бургас беше успешно излекувана 61-годишна жена, заразена с изключително опасната бактерия Вибрио вулнификус, известна още като "бактерия човекоядец". Този случай е първият документиран в България, при който пациент оцелява след заразяване по кръвен път с този патоген.
Фатално наранявание по време на отпуска
Инцидентът се случил по време на почивката на жената на къмпинг Силистар. След като се наранила на крака от шезлонг, тя влязла в морето с открита рана. Още същия ден състоянието ѝ се влошило рязко - кракът ѝ се подул, появили се големи мехури и висока температура.
Спешна намеса и диагностика
При пристигането си в УМБАЛ Бургас, пациентката била прегледана от дежурния хирург д-р Тодор Шуплев. Той разказва: "Установихме инфекция. Последва хирургична обработка на крака, за да не допуснем тя да се разпространи. Взехме и микробиологична проба".
Д-р Калина Цанкова, началник на Микробиологичната лаборатория в болницата, бързо идентифицирала причинителя. "Невъзможно е да объркаш. Тази бактерия е подвижна, характерно е, че не расте в среда, в която растат подобните на нея", обяснява специалистът.
Борба за живота на пациентката
Лечението включвало комбинация от антибиотична терапия и хирургични интервенции. Въпреки първоначалния успех, състоянието на жената се усложнило.
"Имаше момент, в който се появиха симптоми на полиорганна недостатъчност, на сепсис. Жената беше замаяна, не познаваше близките си", споделя д-р Шуплев.
След почти месец интензивно лечение и 10 операции, в които участвал целият състав на Втора хирургия, жената била изписана в добро състояние и без необходимост от ампутация - рядък изход при подобни случаи.
Предупреждение към обществеността
Лекарите от УМБАЛ Бургас отправят важно предупреждение към обществеността: "Хората не предполагат до каква голяма беля може да доведе една раничка. Това е отворена врата за инфекции, затова нека да бъдат внимателни и да не влизат в морето с пресни рани".
Фактори за разпространение на бактерията
Д-р Цанкова коментира, че необичайното разпространение на Вибрио вулнификус вероятно се дължи на изключително горещото лято с малко валежи. Бактерията процъфтява в топли, леко солени води, особено в зоните, където сладководни източници се вливат в морето.
Финансови предизвикателства пред болниците
Лечението на пациентката значително надхвърлило стойността на клиничната пътека. Само медикаментите стрували 9000 лева, без да се включват другите разходи за консумативи, операции и персонал.
"Когато се пита защо държавните болници са в недобро финансово състояние, това е една от причините. На всеки 3-4 месеца имаме по един подобен пациент, който се нуждае от продължително лечение", обясняват от Втора хирургия.
Този уникален случай ще бъде описан в научна публикация и представен на медицински конгрес, допринасяйки за по-доброто разбиране и лечение на инфекциите с Вибрио вулнификус.